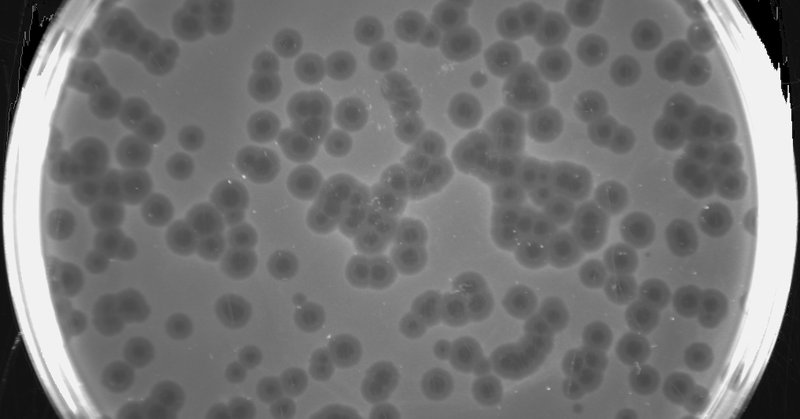

Brian Hie
@BrianHie
Followers
9K
Following
3K
Media
95
Statuses
2K
AI for biology @Stanford and @arcinstitute
San Francisco
Joined October 2011
Welcome to the age of generative genome design! In 1977, Sanger et al. sequenced the first genome—of phage ΦX174. Today, led by @samuelhking, we report the first AI-generated genomes. Using ΦX174 as a template, we made novel, high-fitness phages with genome language models. 🧵
33
213
1K
This Tues (10/14) at 4PM ET, @samuelhking will present "Generative design of novel bacteriophages with genome language models" Paper: https://t.co/ylXGC3aZtV Then, on Wed (10/15) at 4PM ET, @r_krishna3 will give an early-career talk on his research!
biorxiv.org
Many important biological functions arise not from single genes, but from complex interactions encoded by entire genomes. Genome language models have emerged as a promising strategy for designing...
1
8
43
Germinal is a breakthrough in AI-driven antibody design: → Tested only 43 - 101 designs per antigen. → Achieved 4 - 22% hit rates. → Produced nanomolar affinity binders across four diverse targets (PD-L1, IL3, IL20, BHRF1). However, it reveals an alignment problem: structure
1
6
41
Please make me a genome but make it actually good this time.
7
16
155
So so interesting, a very cool addition to the long legacy of ΦX174 as a symbol of the powers and dreams of bioengineers. I wrote about it back in 2015 on the occasion of a synthetic ΦX174 in the Design and Violence show at MoMA:
moma.org
The 5,386 base pairs of φX174’s genome have been mapped, mutated, sequenced, synthesized, and redesigned since the 1950s. φX174 is a virus that infects E. coli, and its abundance, small size, and a…
Welcome to the age of generative genome design! In 1977, Sanger et al. sequenced the first genome—of phage ΦX174. Today, led by @samuelhking, we report the first AI-generated genomes. Using ΦX174 as a template, we made novel, high-fitness phages with genome language models. 🧵
0
1
18
Importantly, Germinal builds on foundational work from @sokrypton ColabDesign, @MartinPacesa BindCraft, and a collection of models and methods developed by the field. This work would not have been possible without their spirit of open science and sharing with the community. 3/n
1
1
10
Excited to share that my PhD thesis work is out in @ScienceMagazine today. We demonstrate robust rearrangement of the human genome using bridge recombinases, performing programmable insertions, excisions, and inversions at megabase-scale.
17
122
835
The FX Super One journey continues - A new chapter of AI-driven mobility in the UAE begins. On Oct 28 at the Armani Hotel Dubai – Burj Khalifa, we unveil the Middle East Final Launch: Super One, Palace of Intelligence. First UAE deliveries begin Nov 2025.
80
54
617
Combine multimer structure prediction and an antibody language model to design de novo antibodies with nanomolar binding affinity. @santimillef @_jnwang @talaldotpdb @driscoll_cl
@haoyu_dai_dhy @Xiaowei0402 @SynBioGaoLab
@BrianHie
2
26
133
For decades, human genome editing has been limited to small, localized modifications. Today, in a new paper published in @ScienceMagazine, researchers from the @pdhsu lab show that bridge recombinase technology is capable of large-scale genomic rearrangements in human cells.
12
168
713
New from @arcinstitute: Megabase scale genome-editing in human cells. Bridge recombinases are a new class of genome editors. In this paper, they were used to invert up to 920,000 base pairs of DNA and also cut out 130,000 base pairs, "with no apparent distance dependency." Let
8
104
481
New from @arcinstitute: Germinal, a generative AI system for antibody design. Fully open source. Good Q&A with the authors below.
4
26
325
Great work by @BrianHie & @SynBioGaoLab labs. Looks like a big leap over SOTA with very clever bootstrapping of design & optimizing using multiple models with complementary strengths & weaknesses. Super expt. validation platform as well.
Today, we report Germinal, a method for efficient de novo antibody design, with @santimillef and @SynBioGaoLab. Germinal achieves success rates of 4-22% across diverse epitopes. We make the work fully open, without doing lame things like posting a preprint without methods. 🧵
1
6
63
"Well, there could be firings and that's their fault. We could cut projects they wanted, favorite projects, and they'd be permanently cut." Tomorrow at 5 PM EST: OAN White House Correspondent @baldwin_daniel_ sits down with President Trump for an exclusive interview. Tune in
128
396
1K
congratulations to @BrianHie and team, IMO the most innovative generative Bio team. Commoditizing and open-sourcing these models will enable a focus and rapid iteration on novel medicines.
Today, we report Germinal, a method for efficient de novo antibody design, with @santimillef and @SynBioGaoLab. Germinal achieves success rates of 4-22% across diverse epitopes. We make the work fully open, without doing lame things like posting a preprint without methods. 🧵
1
7
74
I fucking love this.
Today, we report Germinal, a method for efficient de novo antibody design, with @santimillef and @SynBioGaoLab. Germinal achieves success rates of 4-22% across diverse epitopes. We make the work fully open, without doing lame things like posting a preprint without methods. 🧵
1
4
71
Molecular machine learning is becoming impossible to ignore. New Stanford / Arc collab for generative antibody design. ~4-22% experimental success across targets for de novo nanobody design, including nanomolar binding affinities. What a time to be alive!
6
8
49
Efficient generation of epitope-targeted de novo antibodies with Germinal 1. A groundbreaking study introduces Germinal, a novel computational framework for designing antibodies with nanomolar binding affinities against specific epitopes, requiring only low-throughput
1
9
38
The Supreme Court will hear Wolford v. Lopez, a major gun rights case over Hawaii’s ban on carrying firearms on private property without express permission. The ruling could redefine how Bruen applies—and the limits of state power under the Second Amendment. | Stephen P. Halbrook
1
1
8
Exciting new work from members of our community! Congrats to the Germinal team!
The ability to design antibodies against any protein of interest has major implications for medicine, biotech, and basic science. Today, we introduce Germinal, a pipeline for epitope-targeted de novo antibody design achieving 4–22% success rates with efficient experimental
0
1
16
De novo antibody design with experimental success rates that require testing only tens of candidates! Such an inspiring success from the incredibly hardworking Germinal team— huge congrats!
The ability to design antibodies against any protein of interest has major implications for medicine, biotech, and basic science. Today, we introduce Germinal, a pipeline for epitope-targeted de novo antibody design achieving 4–22% success rates with efficient experimental
1
2
47
largest biology models in the world, AI-generated genomes, and now de novo antibody design arc is the place to do research today
Today, we report Germinal, a method for efficient de novo antibody design, with @santimillef and @SynBioGaoLab. Germinal achieves success rates of 4-22% across diverse epitopes. We make the work fully open, without doing lame things like posting a preprint without methods. 🧵
5
10
100
Donald Trump's illegal third term isn't going to be a presidency, but a religion. February 26, 2026 and 2028 will be crucial dates.
10
8
88